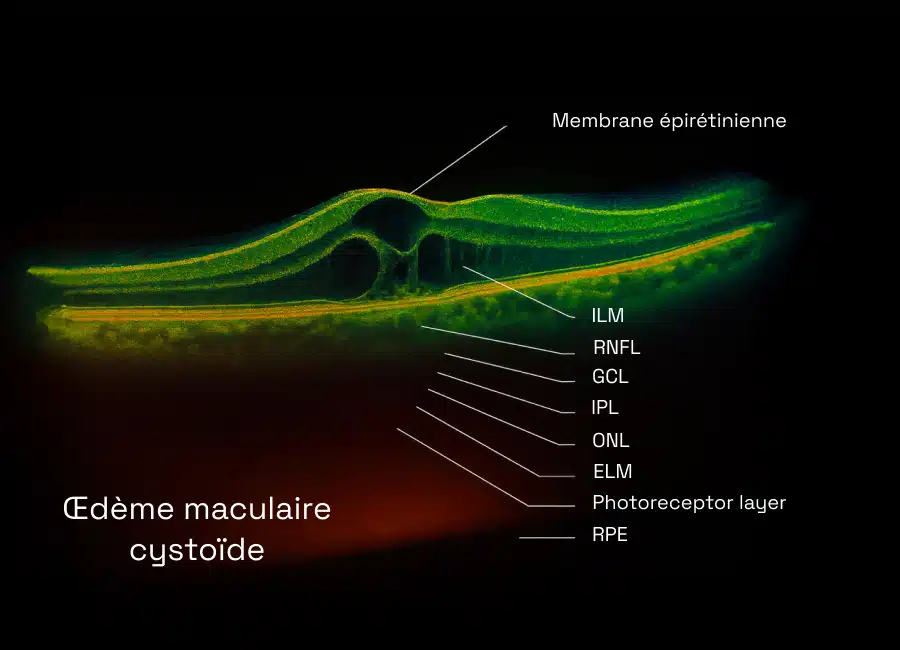

Cette membrane, souvent appelée épimaculaire, perturbe la forme normale de la rétine. En se contractant, elle provoque une traction qui déforme la macula. La vision devient alors floue, déformée ou imprécise. Bien que souvent bénigne, cette pathologie requiert une surveillance spécialisée.
Membrane épirétinienne
La membrane épirétinienne est une fine pellicule fibreuse qui se forme sur la macula, région centrale de la rétine essentielle à la vision nette. Elle provoque une altération visuelle progressive, allant de simples déformations jusqu’à une baisse significative de l’acuité visuelle.
Qu’est-ce que la membrane épirétinienne ?
Quels sont les symptômes d’une membrane épirétinienne ?
Avec le temps, la membrane épirétinienne peut provoquer divers troubles visuels. On observe généralement une vision floue accompagnée d’une baisse d’acuité, des lignes droites qui semblent déformées ou ondulées (phénomène connu sous le nom de métamorphopsies), et parfois une perception exagérée de la taille des objets (macropsie). Dans de rares cas, une vision double (diplopie) peut également apparaître. Ces symptômes perturbent considérablement la vie quotidienne, compliquant des gestes courants comme la lecture, la conduite ou les travaux de précision.
Comment diagnostiquer une membrane épirétinienne ?
Pour détecter une membrane épirétinienne, l’ophtalmologiste combine l’inspection du fond d’œil, à la recherche des signes visibles sur la rétine, avec un examen OCT, capable de repérer et de quantifier la membrane. L’OCT permet notamment de mesurer l’épaisseur membranaire et d’identifier les altérations rétiniennes qu’elle provoque.
Cette protocolisation diagnostique, mise en œuvre au Pôle ophtalmologique Aubergenville, garantit une prise en charge ciblée et efficace.
Quand faut-il opérer une membrane épimaculaire ?
On recommande l’opération lorsque :
- La vision altérée devient un handicap fonctionnel
- Les déformations visuelles perturbent le quotidien
Le geste chirurgical recommandé est une vitrectomie avec ablation de la membrane.
Comment se déroule la chirurgie de la membrane épirétinienne ?
L’opération se fait en ambulatoire, avec sédation légère :
- Retrait du vitré
- Pelage de la membrane à l’aide d’instruments fins
- Injection d’un produit protecteur dans l’œil
La durée de l’intervention est généralement de moins d’une heure.
Les résultats après une vitrectomie
Après la chirurgie :
- Les métamorphopsies régressent
- L’acuité visuelle s’améliore significativement
- La guérison est rapide grâce aux collyres adaptés
La récupération se stabilise sur plusieurs mois avec un faible risque de récidive.
